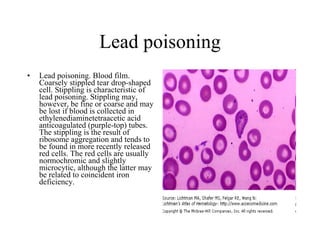
Lead poisoning Lead poisoning. Blood film. Coarsely stippled tear drop-shaped cell. Stippling is characteristic of lead poisoning. Stippling may, however, be fine or coarse and may be lost if blood is collected in ethylenediaminetetraacetic acid anticoagulated (purple-top) tubes. The stippling is the result of ribosome aggregation and tends to be found in more recently released red cells. The red cells are usually normochromic and slightly microcytic, although the latter may be related to coincident iron deficiency.

The document describes several medical imaging findings and pathological specimens related to various pulmonary and renal conditions:
1) Chest x-rays and CT scans showing findings consistent with Goodpasture's syndrome including diffuse bilateral infiltrates, alveolar densities, and lung biopsy findings.
2) Imaging of rheumatoid lung nodules, pneumothorax, and silicosis nodules.
3) Pathology slides of kidney tissue demonstrating Kimmelstiel-Wilson nodules in diabetic nephropathy.






































































![echocardiography There are two major types of echocardiography: M-mode (below left) and two-dimensional (below right) (Fig. 2, [3])](https://image.slidesharecdn.com/picturemedicine-091016122447-phpapp01/85/Picture-Medicine-71-320.jpg)
![echocardiography In the M-mode a single beam of ultrasound is used (Fig. 3, [3]) The reflections of the signal are recorded and displayed as monochronic dots. The location is proportional to the distance from the reflective region, and the intensity contains the information about acoustic impedance of the region. The M-mode has excellent axial resolution, but it carries essentially one-dimensional information. The two-dimensional echocardiograph typically uses a multielement transducer, which generates a single ultrasonic beam with changing direction. This technique allows one to create a two-dimensional image, which has good lateral resolution but lacks accuracy in the axial dimension.](https://image.slidesharecdn.com/picturemedicine-091016122447-phpapp01/85/Picture-Medicine-72-320.jpg)



































![Albright Hereditary Osteodystrophy (AHO). Features of Albright Hereditary Osteodystrophy (AHO). [A] Young woman with short stature (~ 3rd centile), disproportionate shortening of the limbs, generalized obesity, and round, flattened face. [B] Radiograph of the hand showing the shortened 4th and 5th metacarpals. [C] Fist with the characteristic 'dimples' over the 3rd, 4th, and 5th digits replacing the knuckles formed by the distal head of normally sized metacarpal bones (Archibald sign). [D] Brachydactyly of the hand, with the short 4th and 5th digits, the greatly foreshortened terminal 1st digit, and very short, wide thumbnail (potter's thumb).](https://image.slidesharecdn.com/picturemedicine-091016122447-phpapp01/85/Picture-Medicine-108-320.jpg)



















































































































































![cerebral edema [Figure ID: F1] FIGURE 1. CT SCAN SHOWING DIFFUSE CEREBRAL EDEMA IN A YOUNG WOMAN WITH HYPERSENSITIVITY SYNDROME DUE TO MINOCYCLINE.](https://image.slidesharecdn.com/picturemedicine-091016122447-phpapp01/85/Picture-Medicine-256-320.jpg)





























![polyarteritis nodosa. Livedo racemosa (more commonly referred to as livedo reticularis). ( A ) Lacy pattern of discoloration over the lower extremities that does not blanch with pressure in a patient who has polyarteritis nodosa. ( B ) Livedo racemosa, “a tendril-like pattern reminiscent of forked lightning” [30].](https://image.slidesharecdn.com/picturemedicine-091016122447-phpapp01/85/Picture-Medicine-286-320.jpg)